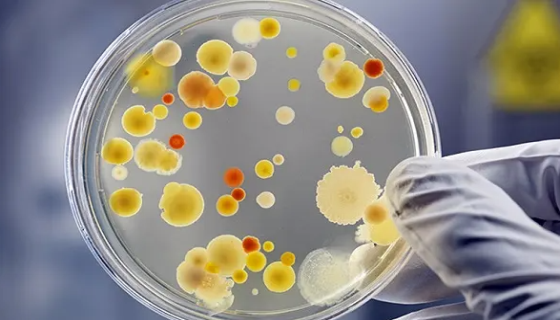
马链球菌兽疫亚种的特征与价值及培养与使用！
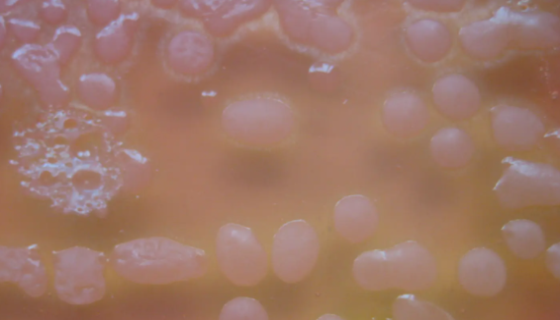
ATCC 10253 密执安棍状杆菌诡谲亚种打管说明！
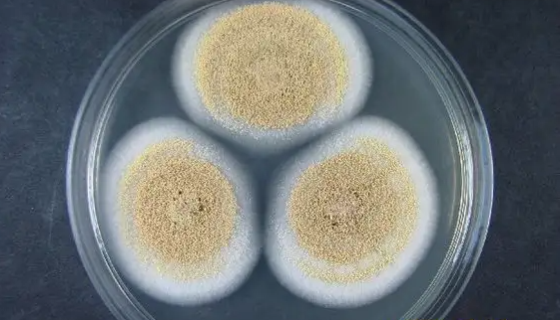
费希尔曲霉的优势特点与培养方法及使用范围！

HT115 人结肠癌细胞的处理方法与培养步骤!
人结肠癌细胞的处理方法与培养步骤及注意事项有哪些?
马链球菌兽疫亚种的特征与价值及培养与使用!
马链球菌兽疫亚种(S.equi subsp. zooepid...

CMT93小鼠结肠癌细胞的处理方法与培养步骤!
小鼠结肠癌细胞接收后的处理方法与培养步骤及注意事项有哪些?
ATCC 10253 密执安棍状杆菌诡谲亚种打管说明!
密执安棍状杆菌诡谲亚种属于微球菌科密执安棍状杆菌属真菌的一种...
费希尔曲霉的优势特点与培养方法及使用范围!
费希尔曲霉是属于杯霉科的一种。壳霉目杯霉科微生物,主要用于教...

HepaRG (人肝癌细胞)的常规培养与传代流程!
人肝癌细胞HepaRG取自女性供体,贴壁培养。仅用于科学研究...

猫巨噬细胞的培养方式与质量检测及注意事项!
猫巨噬细胞Fcwf-4取自雌性胎猫,仅用于科学研究或者工业应...

U-87MG/U87MG 人脑星形胶质母细胞瘤细胞
人脑星形胶质母细胞瘤细胞由PontenJ等建立,源于恶性神经...

祝贺我司用户发表关于乳杆菌的文章获得了奖励!
祝贺我司用户发表关于乳杆菌的文章获得了奖励!